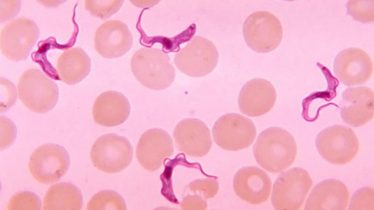

社会問題
社会問題 学歴による社会の分断 「日本人の3人に1人は日本語が読めない」調査結果も
学歴による社会の分断 「日本人の3人に1人は日本語が読めない」調査結果も 信じられないことだが本当のようです。 知識社会においては学歴によって社会が分断され、知能の格差が経済格差につながるという残酷な側面がある。そうした中で、「初歩的な事務...
 社会問題
社会問題  コロナワクチン
コロナワクチン  コロナワクチン
コロナワクチン  アセンション
アセンション  アセンション
アセンション  アセンション
アセンション コロナワクチン
コロナワクチン  アセンション
アセンション